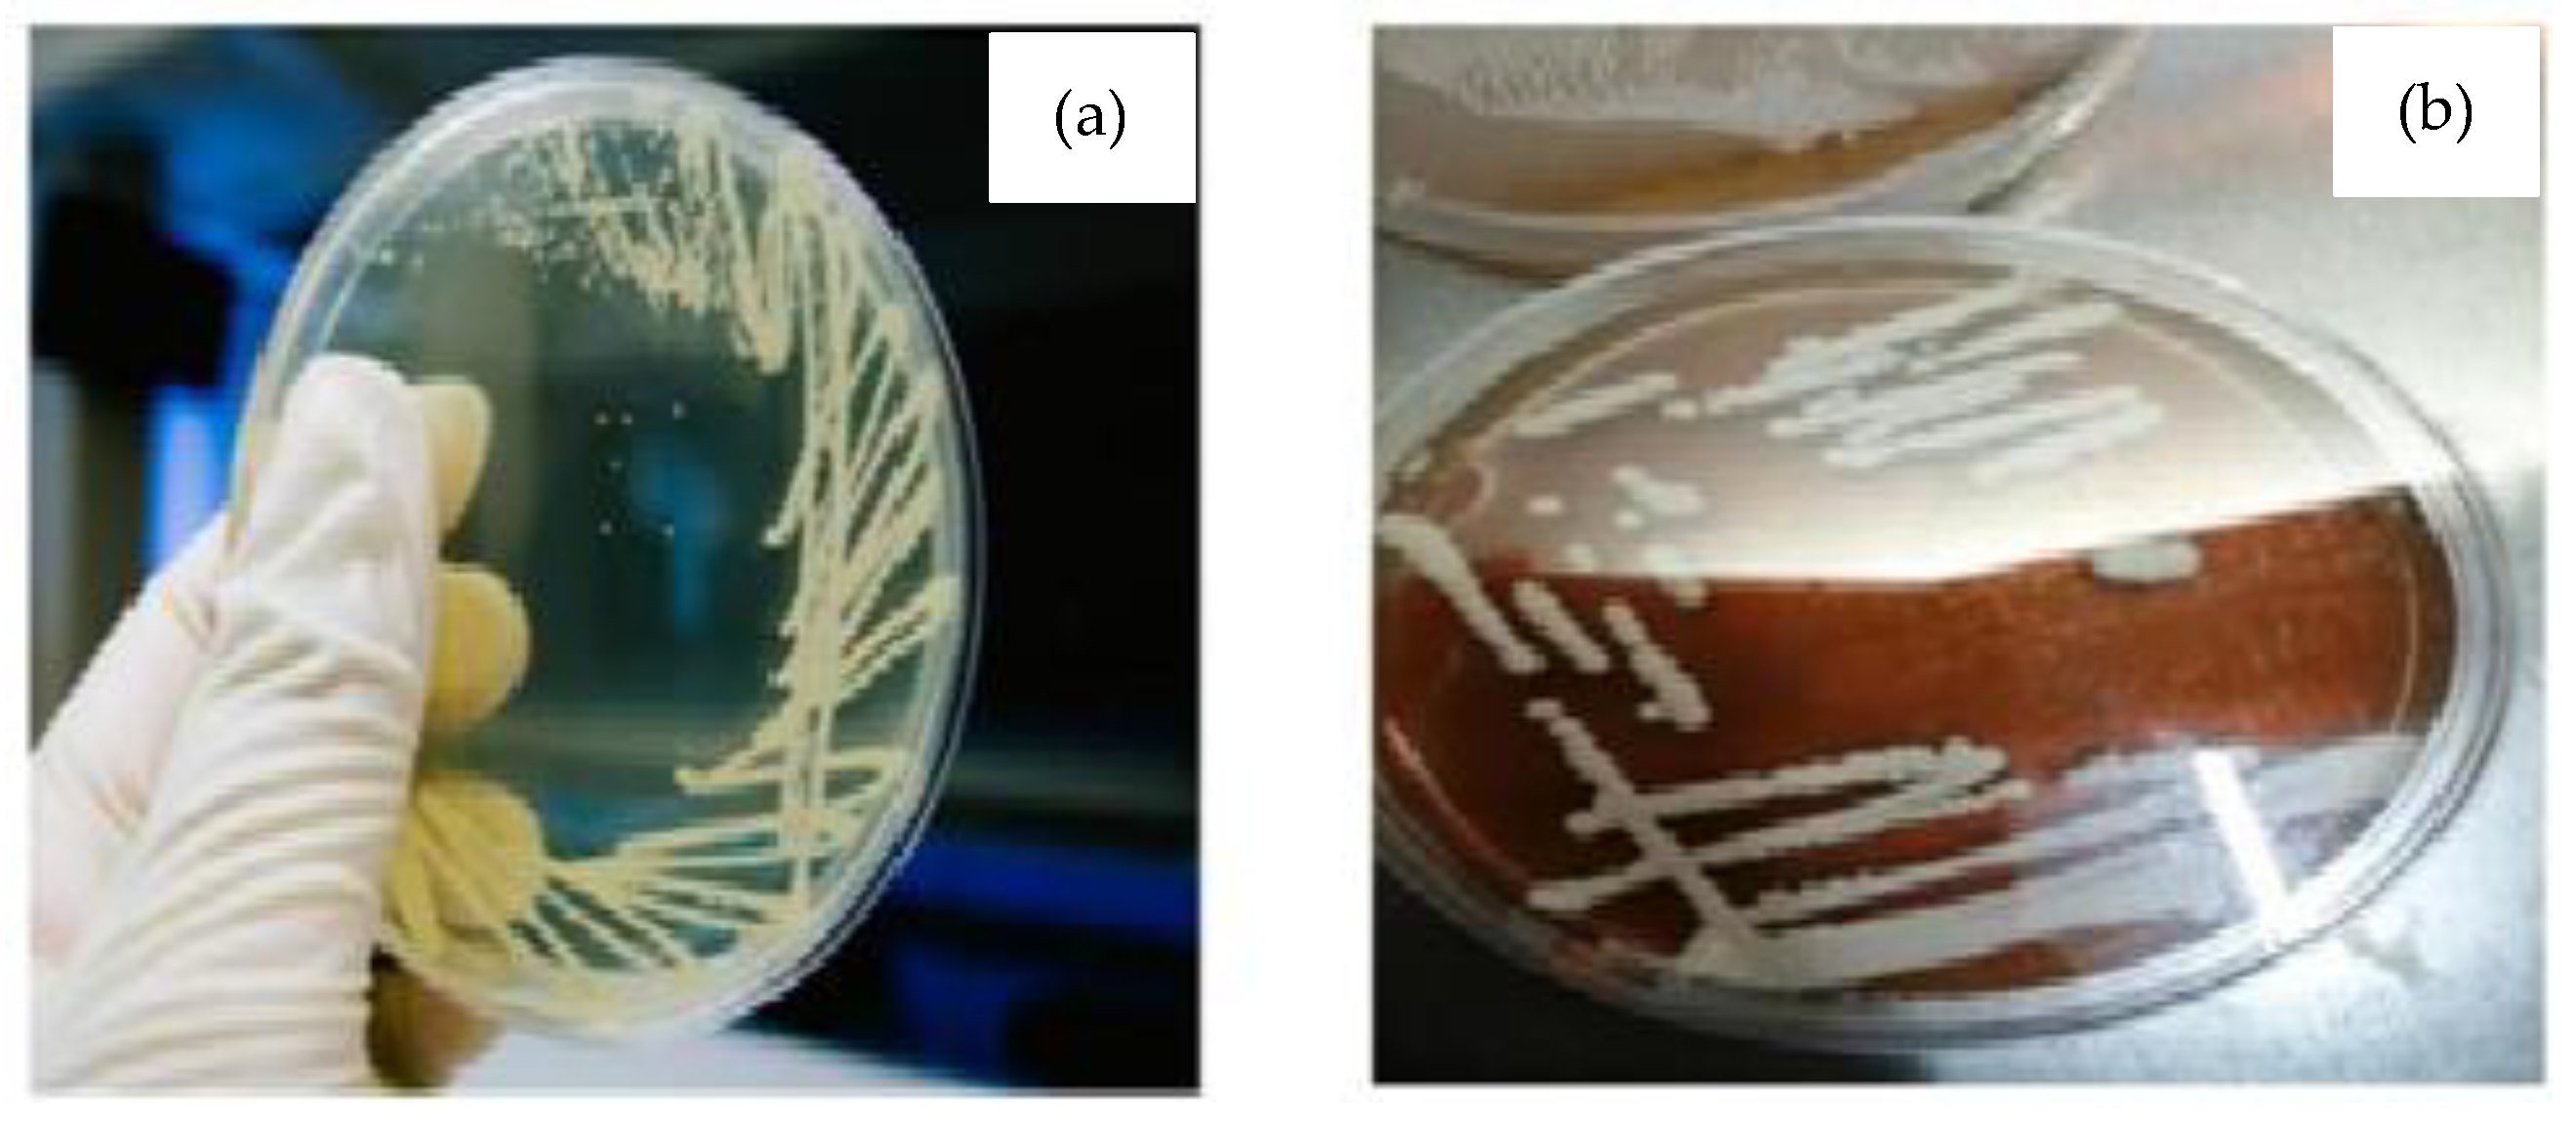
Energies 16 02181 g002 Energies 16 02181 g002

Enzymatic Co-Fermentation of Onion Waste for Bioethanol Production Using Saccharomyces cerevisiae and Pichia pastoris
Abstract
1. Introduction
2. Methodology
2.1. Feedstock Preparation
2.2. Cultivation of Yeast Strains
2.3. Fermentation for Bioethanol Production
2.4. Productivity and Energy Content Estimation
2.5. Analytical Methods
2.5.1. Reducing Sugar Test
2.5.2. FTIR Analysis
2.5.3. GC-FID Analysis
3. Results and Discussion
3.1. Reducing Sugar Analysis
3.2. Results of FTIR Analysis
3.3. Bioethanol Concentration
3.3.1. Bioethanol Production Using S. cerevisiae
3.3.2. Bioethanol Production Using P. pastoris
3.3.3. Bioethanol Production Using Co-Culture Strains
4. Conclusions
Author Contributions
Funding
Data Availability Statement
Conflicts of Interest
References
- Benni, S.D.; Munnolli, R.S.; Katagi, K.S.; Kadam, N.S.; Akki, M.C. Liquid fuel synthesis from Leonotis nepetifolia seeds through in-situ transesterification method. Energy Sources Part A Recover. Util. Environ. Eff. 2020, 1–18. [Google Scholar] [CrossRef]
- Ganguly, P.; Khan, A.; Das, P.; Bhowal, A. Cellulose from lignocellulose kitchen waste and its application for energy and environment: Bioethanol production and dye removal. Indian Chem. Eng. 2020, 63, 161–171. [Google Scholar] [CrossRef]
- Krzywanski, J.; Ashraf, W.M.; Czakiert, T.; Sosnowski, M.; Grabowska, K.; Zylka, A.; Kulakowska, A.; Skrobek, D.; Mistal, S.; Gao, Y. CO2 Capture by Virgin Ivy Plants Growing Up on the External Covers of Houses as a Rapid Complementary Route to Achieve Global GHG Reduction Targets. Energies 2022, 15, 1683. [Google Scholar] [CrossRef]
- Deng, Y.; Qiu, L.; Shao, Y.; Yao, Y. Process Modeling and Optimization of Anaerobic Co-Digestion of Peanut Hulls and Swine Manure Using Response Surface Methodology. Energy Fuels 2019, 33, 11021–11033. [Google Scholar] [CrossRef]
- König, A.; Ulonska, K.; Mitsos, A.; Viell, J. Optimal Applications and Combinations of Renewable Fuel Production from Biomass and Electricity. Energy Fuels 2019, 33, 1659–1672. [Google Scholar] [CrossRef]
- Li, P.; Liu, Z.; Zhao, M.; Dai, X.; Ruan, W. Evaluation of biogas performance and process stability from food, kitchen, and fruit/vegetable waste by mono-, co- and tri-digestion. Energy Fuels 2020, 34, 12734–12742. [Google Scholar] [CrossRef]
- Tri, C.L.; Kamei, I. Butanol production from cellulosic material by anaerobic co-culture of white-rot fungus Phlebia and bacterium Clostridium in consolidated bioprocessing. Bioresour. Technol. 2020, 305, 123065. [Google Scholar] [CrossRef]
- Hrůzová, K.; Matsakas, L.; Karnaouri, A.; Norén, F.; Rova, U.; Christakopoulos, P. Second-Generation Biofuel Production from the Marine Filter Feeder Ciona intestinalis. ACS Sustain. Chem. Eng. 2020, 8, 8373–8380. [Google Scholar] [CrossRef]
- Kolosz, B.W.; Luo, Y.; Xu, B.; Maroto-Valer, M.M.; Andresen, J.M. Life cycle environmental analysis of ‘drop in’ alternative aviation fuels: A review. Sustain. Energy Fuels 2020, 4, 3229–3263. [Google Scholar] [CrossRef]
- Sondhi, S.; Kaur, P.S.; Kaur, M. Techno-economic analysis of bioethanol production from microwave pretreated kitchen waste. SN Appl. Sci. 2020, 2, 1–13. [Google Scholar] [CrossRef]
- Taghizadeh-Alisaraei, A.; Assar, H.A.; Ghobadian, B.; Motevali, A. Potential of biofuel production from pistachio waste in Iran. Renew. Sustain. Energy Rev. 2017, 72, 510–522. [Google Scholar] [CrossRef]
- Mohapatra, S.; Mishra, R.R.; Nayak, B.; Behera, B.C.; Das Mohapatra, P.K. Development of co-culture yeast fermentation for efficient production of biobutanol from rice straw: A useful insight in valorization of agro industrial residues. Bioresour. Technol. 2020, 318, 124070. [Google Scholar] [CrossRef]
- Choksi, H.; Pandian, S.; Arumugamurthi, S.S.; Sivanandi, P.; Sircar, A.; Booramurthy, V.K. Production of biodiesel from high free fatty acid feedstock using heterogeneous acid catalyst derived from palm-fruit-bunch. Energy Sources Part A Recover. Util. Environ. Eff. 2019, 43, 3393–3402. [Google Scholar] [CrossRef]
- Kriger, O.; Budenkova, E.; Babich, O.; Suhih, S.; Patyukov, N.; Masyutin, Y.; Dolganuk, V.; Chupakhin, E. The Process of Producing Bioethanol from Delignified Cellulose Isolated from Plants of the Miscanthus Genus. Bioengineering 2020, 7, 61. [Google Scholar] [CrossRef] [PubMed]
- Yadaw, R.K.; Shahi, S.K. Fatty acid profiling through gas chromatography mass spectrophotometry (GC-MS) of chlorella vulgaris as potential feedstock for biofuel production. Plant Arch. 2020, 20, 6039–6045. [Google Scholar]
- Chen, J.; Li, S. Characterization of biofuel production from hydrothermal treatment of hyperaccumulator waste (Pteris vittata L.) in sub- and supercritical water. RSC Adv. 2020, 10, 2160–2169. [Google Scholar] [CrossRef]
- Froese, A.G.; Nguyen, T.-N.; Ayele, B.T.; Sparling, R. Digestibility of Wheat and Cattail Biomass Using a Co-culture of Thermophilic Anaerobes for Consolidated Bioprocessing. BioEnergy Res. 2020, 13, 325–333. [Google Scholar] [CrossRef]
- Kumari, D.; Singh, R. Pretreatment of lignocellulosic wastes for biofuel production: A critical review. Renew. Sustain. Energy Rev. 2018, 90, 877–891. [Google Scholar] [CrossRef]
- Skaggs, R.L.; Coleman, A.M.; Seiple, T.E.; Milbrandt, A.R. Waste-to-Energy biofuel production potential for selected feedstocks in the conterminous United States. Renew. Sustain. Energy Rev. 2018, 82, 2640–2651. [Google Scholar] [CrossRef]
- Sarkar, M.; Sarkar, B. How does an industry reduce waste and consumed energy within a multi-stage smart sustainable biofuel production system? J. Clean. Prod. 2020, 262, 121200. [Google Scholar] [CrossRef]
- Razaghi, A.; Karthikeyan, O.; Hao, H.N.; Heimann, K. Hydrolysis treatments of fruit and vegetable waste for production of biofuel precursors. Bioresour. Technol. 2016, 217, 100–103. [Google Scholar] [CrossRef]
- Rago, Y.P.; Surroop, D.; Mohee, R. Assessing the potential of biofuel (biochar) production from food wastes through thermal treatment. Bioresour. Technol. 2018, 248, 258–264. [Google Scholar] [CrossRef] [PubMed]
- Searle, S.Y.; Malins, C.J. Waste and residue availability for advanced biofuel production in EU Member States. Biomass-Bioenergy 2016, 89, 2–10. [Google Scholar] [CrossRef]
- Elsayed, M.; Ran, Y.; Ai, P.; Azab, M.; Mansour, A.; Jin, K.; Zhang, Y.; Abomohra, A.E.-F. Innovative integrated approach of biofuel production from agricultural wastes by anaerobic digestion and black soldier fly larvae. J. Clean. Prod. 2020, 263, 121495. [Google Scholar] [CrossRef]
- Thangavelu, S.K.; Ahmed, A.S.; Ani, F.N. Bioethanol production from sago pith waste using microwave hydrothermal hydrolysis accelerated by carbon dioxide. Appl. Energy 2014, 128, 277–283. [Google Scholar] [CrossRef]
- Fernández, J.D. La Industria 4.0: Una Revisión de la Literatura. In Desarrollo e Innovación en Ingeniería. 2017. Available online: https://www.researchgate.net/profile/Edgar_Serna_M/publication/331385353_Desarrollo_e_innovacion_en_ingenieria_ed_2/links/5c76e4ce92851c69504663b5/Desarrollo-e-innovacion-en-ingenieria-ed-2.pdf#page=379 (accessed on 20 September 2022).
- Manmai, N.; Unpaprom, Y.; Ramaraj, R. Bioethanol production from sunflower stalk: Application of chemical and biological pretreatments by response surface methodology (RSM). Biomass-Convers. Biorefinery 2020, 11, 1759–1773. [Google Scholar] [CrossRef]
- Jahanbakhshi, A.; Salehi, R. Processing watermelon waste using Saccharomyces cerevisiae yeast and the fermentation method for bioethanol production. J. Food Process. Eng. 2019, 42, e13283. [Google Scholar] [CrossRef]
- Zhang, Y.; Wang, C.; Wang, L.; Yang, R.; Hou, P.; Liu, J. Direct bioethanol production from wheat straw using xylose/glucose co-fermentation by co-culture of two recombinant yeasts. J. Ind. Microbiol. Biotechnol. 2017, 44, 453–464. [Google Scholar] [CrossRef] [PubMed]
- Sztekler, K.; Kalawa, W.; Nowak, W.; Mika, L.; Gradziel, S.; Krzywanski, J.; Radomska, E. Experimental Study of Three-Bed Adsorption Chiller with Desalination Function. Energies 2020, 13, 5827. [Google Scholar] [CrossRef]
- Idziak, K.; Czakiert, T.; Krzywanski, J.; Zylka, A.; Kozlowska, M.; Nowak, W. Safety and environmental reasons for the use of Ni-, Co-, Cu-, Mn- and Fe-based oxygen carriers in CLC/CLOU applications: An overview. Fuel 2020, 268, 117245. [Google Scholar] [CrossRef]
- Muskała, W.; Krzywański, J.; Sekret, R.; Nowak, W. Model research of coal combustion in circulating fluidized bed boilers. Chem. Process Eng.—Inz. Chem. Proces. 2008, 29, 473–492. [Google Scholar]
- Zylka, A.; Krzywanski, J.; Czakiert, T.; Idziak, K.; Sosnowski, M.; Grabowska, K.; Prauzner, T.; Nowak, W. The 4th generation of CeSFaMB in numerical simulations for CuO-based oxygen carrier in CLC system. Fuel 2019, 255, 115776. [Google Scholar] [CrossRef]
- Bouckaert, S.; Pales, A.F.; McGlade, C.; Remme, U.; Wanner, B.; Varro, L.; D’Ambrosio, D.; Spencer, T. Net Zero by 2050: A Roadmap for the Global Energy Sector; The National Academies of Sciences, Engineering, and Medicine: Washington, DC, USA, 2021. [Google Scholar]
- Krzywanski, J.; Czakiert, T.; Zylka, A.; Nowak, W.; Sosnowski, M.; Grabowska, K.; Skrobek, D.; Sztekler, K.; Kulakowska, A.; Ashraf, W.M.; et al. Modelling of SO2 and NOx Emissions from Coal and Biomass Combustion in Air-Firing, Oxyfuel, iG-CLC, and CLOU Conditions by Fuzzy Logic Approach. Energies 2022, 15, 8095. [Google Scholar] [CrossRef]
- Krzywanski, J. Heat Transfer Performance in a Superheater of an Industrial CFBC Using Fuzzy Logic-Based Methods. Entropy 2019, 21, 919. [Google Scholar] [CrossRef]
- Krzywanski, J.; Urbaniak, D.; Otwinowski, H.; Wylecial, T.; Sosnowski, M. Fluidized Bed Jet Milling Process Optimized for Mass and Particle Size with a Fuzzy Logic Approach. Materials 2020, 13, 3303. [Google Scholar] [CrossRef]

Disclaimer/Publisher’s Note: The statements, opinions and data contained in all publications are solely those of the individual author(s) and contributor(s) and not of MDPI and/or the editor(s). MDPI and/or the editor(s) disclaim responsibility for any injury to people or property resulting from any ideas, methods, instructions or products referred to in the content. |
© 2023 by the authors. Licensee MDPI, Basel, Switzerland. This article is an open access article distributed under the terms and conditions of the Creative Commons Attribution (CC BY) license (https://creativecommons.org/licenses/by/4.0/).
Share and Cite
Shahid, I.; Hussain, G.; Anis, M.; Farooq, M.U.; Usman, M.; Fouad, Y.; Krzywanski, J. Enzymatic Co-Fermentation of Onion Waste for Bioethanol Production Using Saccharomyces cerevisiae and Pichia pastoris. Energies 2023, 16, 2181. https://doi.org/10.3390/en16052181
Shahid I, Hussain G, Anis M, Farooq MU, Usman M, Fouad Y, Krzywanski J. Enzymatic Co-Fermentation of Onion Waste for Bioethanol Production Using Saccharomyces cerevisiae and Pichia pastoris. Energies. 2023; 16(5):2181. https://doi.org/10.3390/en16052181
Chicago/Turabian StyleShahid, Iqra, Ghulam Hussain, Mehwish Anis, Muhammad Umar Farooq, Muhammad Usman, Yasser Fouad, and Jaroslaw Krzywanski. 2023. "Enzymatic Co-Fermentation of Onion Waste for Bioethanol Production Using Saccharomyces cerevisiae and Pichia pastoris" Energies 16, no. 5: 2181. https://doi.org/10.3390/en16052181
APA StyleShahid, I., Hussain, G., Anis, M., Farooq, M. U., Usman, M., Fouad, Y., & Krzywanski, J. (2023). Enzymatic Co-Fermentation of Onion Waste for Bioethanol Production Using Saccharomyces cerevisiae and Pichia pastoris. Energies, 16(5), 2181. https://doi.org/10.3390/en16052181

